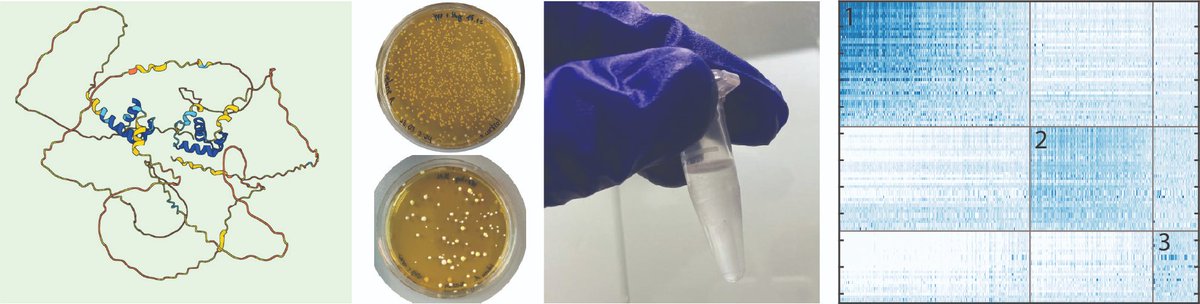
Join our Group ! We are looking for one PhD student to explore the "Molecular Basis of Transcription Factor Evolution". Find out more here and apply: drive.google.com/file/d/1nd_pPv…

FJonas
@fjonas15
join me on bluesky: @fejonas.bsky.social
ID: 1272924161627828229
16-06-2020 16:09:17
83 Tweet
93 Followers
139 Following



Friends, Romans, Transcriptionmen, this is not to be missed. Free access live and online. October 10th Université de Genève


Very excited to share our work and my first ever paper!🎉🎉 Super grateful to Yoav Voichek (plant-trx.bsky.social) and many other people for making it happen Take a look to read about our findings in the cell cycle status of developing gametes Plant Physiology academic.oup.com/plphys/advance…

New preprint! Engineered bacteria launch and control an oncolytic virus biorxiv.org/content/10.110… Exciting work from Zak Singer jpabon & lab engineering bacteria to deliver viral RNAs that launch viral spread. We also engineer the virus to depend on bacteria. Congrats all!



Check out our new paper: “Intrinsically disordered regions of the Msn2 transcription factor encode multiple functions using interwoven sequence grammars” published Nucleic Acids Res. The work of Vladimir Mindel and Sagie Brodsky. academic.oup.com/nar/advance-ar…

Exciting news! Our latest paper "Ordered and disordered regions of the Origin Recognition Complex direct differential in vivo binding at distinct motif sequences", led by Michal Chappleboim is now out in Nucleic Acids Res. Check out the highlights below. doi.org/10.1093/nar/gk…


🎉Happy to share our new paper! Intrinsically disordered regions (IDRs) in transcription factors (TFs) encode for complex binding patterns using diverse sequence grammars and interaction types. (1/9) academic.oup.com/nar/advance-ar… Bohdana Hurieva🇺🇦 Divya Krishna Kumar guided by FJonas Naama Barkai


(1/13) Exciting findings from our latest study, now published in Nucleic Acids Res as a breakthrough article! academic.oup.com/nar/advance-ar…

Finally out!!! Vladimir Mindel I was so lucky to work with you.

I really like the simple model for Transcription Factor function: "DNA binding - Mediator recruitment - Gene activation." But this elegant and systematic study from Vladimir Mindel +Sagie Brodsky, Barkai Lab provides an exciting fresh perspective. Highly recommended!



Paper alert: Congratulations to PhD student, now Dr. Aryeh Solomon for this great work, published eLife - the journal. Can a BCG vaccine also protect from Gram-negative infection? #TrainedImmunity Thanks also to long time collaborator Mihai Netea and other friends. doi.org/10.7554/eLife.…